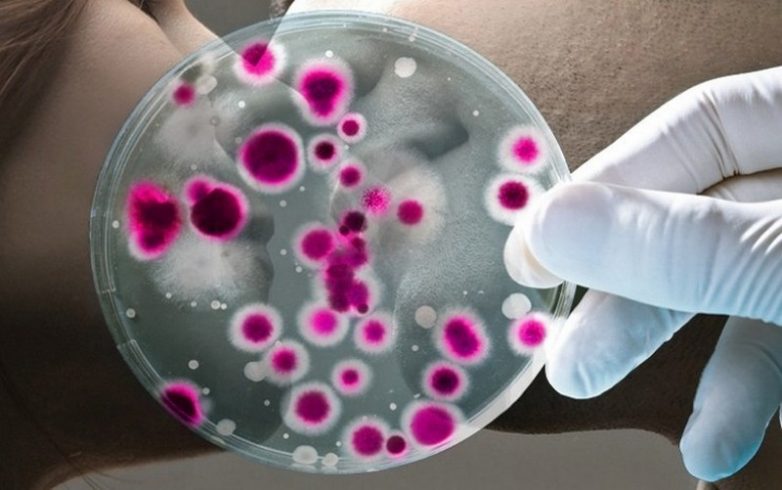

10 распространённых мифов о простуде
Мы все росли с различными представлениями о простуде и её лечении, согласитесь, некоторые из них довольно изобретательны, но большинство известных фактов являются заблуждениями. С помощью данного списка мы расскажем о десяти распространённых мифах, связанных с простудой. Надеемся, это поможет вам лучше подготовиться и справиться с насморком и кашлем в будущем.


Мы всё это делали или, по крайней мере, видели, как это делают другие. Нужно накрыть голову полотенцем или покрывалом и держать её над горячей водой (в простонародии говорят «дышать над картошкой»), в воду можно добавить эфирное масло и отвар трав. К сожалению, доказано, что этот способ не работает. Но иногда он может облегчить симптомы, и вы будете чувствовать себя лучше, но ненадолго.

Многие люди считают, что можно заболеть гриппом от инъекции. Этот миф пошёл от заблуждения, что вакцина против гриппа содержит ослабленную форму самого вируса. Однако на самом деле она включает только компоненты вируса, а не полный его вариант.

Ослабленная иммунная система не повышает риск заболевания простудой. Здоровые и больные люди проявляют одинаковую восприимчивость к простудным заболеваниям, это было научно доказано.
Ещё один интересный факт, который показало исследование – из всех людей, принимающих в нём участие, заразилось 95%, но только у 75% из них проявлялись какие-либо симптомы. Такая простуда называется «бессимптомной».

Это распространённый миф, будто очень много витамина С и цинка помогут предотвратить (или вылечить) простуду. Это, конечно, очень хорошая идея принимать витаминные и минеральные добавки, но на вирус простуды они не имеют никакого влияния, добавки лишь помогают восполнить организму запас веществ, находящиеся в дефиците.

Ещё один известный миф гласит, что легче всего «подхватить» простуду в зимний период. Однако проще всего заболеть весной и осенью. Потому, что вирус становится гораздо более активным именно в эти сезоны, а зимой он наоборот — наиболее спокойный.

Многие люди думают, что пить молоко при простуде плохая идея, потому что оно оседает на слизистой оболочке. На самом деле, молоко не накапливается на слизистой вообще. Вы можете смело пить его столько, сколько хотите, и оно никоим образом не навредит.

Поцелуй не так заразен, как мы думаем. Самая большая угроза на самом деле исходит из нашего насморка. Секреция носа является защитной реакцией на различные вирусы и бактерии, но часто она также становится причиной заражения. Тем не менее, лучше ограничиться в поцелуях.

Большинство людей думает, что если не выходить на улицу с мокрыми волосами и всегда тепло одеваться, то они никогда не простудятся. На самом деле, небольшие перепады температуры тела в контрасте с температурой окружающей среды не играют никакой роли (если не считать низких температур, опасных для жизни). Вы простужаетесь, когда контактируете с вирусом, он попадает в организм и только так можно заболеть. По большей части не имеет никакого значения жарко вам, холодно, тепло или сухо.

Многие люди считают, что симптомы простуды (насморк, кашель и т. д.) проявляются, чтобы помочь нам определить и вылечить болезнь быстрее. Поэтому они не верят, что мы должны лечить симптомы с помощью медикаментов.
Правда в том, что симптомы не только не влияют на продолжительность простуды, они могут способствовать распространению вируса на других людей. Вы должны осознать, что лекарственные средства, облегчающие симптомы простуды, не только помогают легче перенести болезнь, но и предотвращают её распространение на других.

Есть такое выражение «Кормить вирус». Это значит, что с едой мы якобы даём питательные вещества вирусу, а не организму. Это совершенно не соответствует действительности. Еда не имеет никакого отрицательного влияния на организм при болезни, на самом деле всё, наоборот.

Дышать над паром

Мы всё это делали или, по крайней мере, видели, как это делают другие. Нужно накрыть голову полотенцем или покрывалом и держать её над горячей водой (в простонародии говорят «дышать над картошкой»), в воду можно добавить эфирное масло и отвар трав. К сожалению, доказано, что этот способ не работает. Но иногда он может облегчить симптомы, и вы будете чувствовать себя лучше, но ненадолго.
Прививка от гриппа

Многие люди считают, что можно заболеть гриппом от инъекции. Этот миф пошёл от заблуждения, что вакцина против гриппа содержит ослабленную форму самого вируса. Однако на самом деле она включает только компоненты вируса, а не полный его вариант.
Слабая иммунная система

Ослабленная иммунная система не повышает риск заболевания простудой. Здоровые и больные люди проявляют одинаковую восприимчивость к простудным заболеваниям, это было научно доказано.
Ещё один интересный факт, который показало исследование – из всех людей, принимающих в нём участие, заразилось 95%, но только у 75% из них проявлялись какие-либо симптомы. Такая простуда называется «бессимптомной».
Большие дозы витамина С

Это распространённый миф, будто очень много витамина С и цинка помогут предотвратить (или вылечить) простуду. Это, конечно, очень хорошая идея принимать витаминные и минеральные добавки, но на вирус простуды они не имеют никакого влияния, добавки лишь помогают восполнить организму запас веществ, находящиеся в дефиците.
Зимние холода

Ещё один известный миф гласит, что легче всего «подхватить» простуду в зимний период. Однако проще всего заболеть весной и осенью. Потому, что вирус становится гораздо более активным именно в эти сезоны, а зимой он наоборот — наиболее спокойный.
Не пить молоко

Многие люди думают, что пить молоко при простуде плохая идея, потому что оно оседает на слизистой оболочке. На самом деле, молоко не накапливается на слизистой вообще. Вы можете смело пить его столько, сколько хотите, и оно никоим образом не навредит.
Не целоваться
Поцелуй не так заразен, как мы думаем. Самая большая угроза на самом деле исходит из нашего насморка. Секреция носа является защитной реакцией на различные вирусы и бактерии, но часто она также становится причиной заражения. Тем не менее, лучше ограничиться в поцелуях.
Причина простуды — холод

Большинство людей думает, что если не выходить на улицу с мокрыми волосами и всегда тепло одеваться, то они никогда не простудятся. На самом деле, небольшие перепады температуры тела в контрасте с температурой окружающей среды не играют никакой роли (если не считать низких температур, опасных для жизни). Вы простужаетесь, когда контактируете с вирусом, он попадает в организм и только так можно заболеть. По большей части не имеет никакого значения жарко вам, холодно, тепло или сухо.
Не лечить симптомы

Многие люди считают, что симптомы простуды (насморк, кашель и т. д.) проявляются, чтобы помочь нам определить и вылечить болезнь быстрее. Поэтому они не верят, что мы должны лечить симптомы с помощью медикаментов.
Правда в том, что симптомы не только не влияют на продолжительность простуды, они могут способствовать распространению вируса на других людей. Вы должны осознать, что лекарственные средства, облегчающие симптомы простуды, не только помогают легче перенести болезнь, но и предотвращают её распространение на других.
Кормить вирус

Есть такое выражение «Кормить вирус». Это значит, что с едой мы якобы даём питательные вещества вирусу, а не организму. Это совершенно не соответствует действительности. Еда не имеет никакого отрицательного влияния на организм при болезни, на самом деле всё, наоборот.
Только зарегистрированные и авторизованные пользователи могут оставлять комментарии.
0
"… можно заболеть гриппом от инъекции". В 80-х класс прививали, через 3 дня 70% на больничном.
- ↓
+1
«Многие люди считают, что можно заболеть гриппом от инъекции. Этот миф пошёл от заблуждения, что вакцина против гриппа содержит ослабленную форму самого вируса.» Лет пятнадцать сделал прививку от гриппа — свалился на несколько дней… Никаких прививок не делал все эти годы — в мае коронавирус перенес без симптомов «на ногах»!
- ↓
+1
Заблуждений никаких нигде нет, есть намеренный и преступный обман с говновирусами
- ↓

